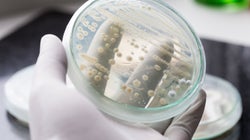

Οι αρχές προειδοποιούν: Προσοχή, θα βρέξει ιγκουάνα στη Ν. Φλόριντα

Ακούγεται σαν fake news, αλλά για τους κατοίκους της Νότιας Φλόριντα των ΗΠΑ δεν είναι κάτι καινούργιο. Οταν η θερμοκρασία πέφτει γύρω ή κάτω από το μηδέν, τα ιγκουάνα πέφτουν παγωμένα από τον ουρανό.
Για την ακρίβεια, πέφτουν από τα δένδρα στα οποία ανεβαίνουν το βράδυ για να κοιμηθούν.
Η Εθνική Μετεωρολογική Υπηρεσία του Μαϊάμι εξέδωσε προειδοποίηση για τη Νότια Φλόριντα τα ξημερώματα της 22ης Ιανουαρίου (ώρα Ελλάδος) προετοιμάζοντας τους κατοίκους της περιοχής για την πιθανή «βροχή» των ιγκουάνα.
«Μην εκπλαγείτε αν δείτε ιγκουάνα να πέφτουν από τα δένδρα απόψε, καθώς η θερμοκρασία αναμένεται να πέσει γύρω στο μηδέν. Μπρρρ!» ήταν η ανακοίνωση στο Twitter.
Τα ιγκουάνα σκαρφαλώνουν στα δένδρα το βράδυ για να κοιμηθούν, αλλά όταν η θερμοκρασία πέφτει, ο οργανισμός τους «κλείνει» λόγω κρύου και παραλύουν, με αποτέλεσμα να μην μπορούν να κρατηθούν πάνω στα κλαριά και τους κορμούς και να πέφτουν στο έδαφος από ύψος.
Τα ιγκουάνα, που μπορεί να φτάσουν και το ενάμιση μέτρο σε μήκος, είναι είδος που έχει «εισαχθεί» στη Νότια Φλόριντα και δεν αντέχουν το κρύο. Οι χαμηλές θερμοκρασίες ναι μεν τα παραλύουν, αλλά δεν είναι απαραίτητο να τα σκοτώσουν. Μόλις επανέρχεται η ζέστη, επανέρχονται και αυτά.
Σύμφωνα με τους ειδικούς, ακόμα κι αν φαίνονται εντελώς άψυχα, μόλις εκτεθούν στη ζέστη και στην ηλιακή ακτινοβολία, ξαναζωντανεύουν. Κι όσα επιζούν, μεταδίδουν το συγκεκριμένο γονίδιο από γενιά σε γενιά.